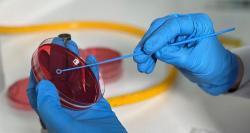

En esta columna, Alin Casado, miembro de la directiva de Women in Chilean Aquaculture (WICA), presidenta de MEVEA y BioFarm Health Manager en BioMar Chile, reflexiona sobre el origen histórico del Día Internacional de la Mujer y analiza las brechas laborales que aún enfrentan las mujeres en el mundo del trabajo, incluyendo desigualdad salarial, acceso a cargos de liderazgo y situaciones de discriminación, con énfasis en los desafíos que persisten en sectores productivos como la acuicultura.
Mevea
El Sea Lice Conference 2025 dedicó un homenaje a la investigadora Gladys Asencio, destacando su legado en el estudio del Caligus rogercresseyi, su labor formadora y su aporte a la ciencia marina en Chile.
El Centro de Estudios para la Acuicultura Sustentable participó activamente en LACQUA 2025, con ponencias de la Dra. Alicia Gallardo, el Dr. Jurij Wacyk y el Dr. José Manuel Yáñez, reafirmando su liderazgo regional en investigación y bienestar animal.
MEVEA celebró el Día del Médico Veterinario en LACQUA 2025 destacando el trabajo multidisciplinario y la innovación acuícola.
MEVEA dio a conocer el programa preliminar del Seminario Día del Médico Veterinario 2025, que se realizará en LACQUA en Puerto Varas.
MEVEA celebró el Día del Veterinario con una jornada de charlas sobre desafíos y avances en la salmonicultura en Puerto Varas.
La directiva de MEVEA ha preparado una serie de actividades que se llevarán a cabo el viernes 11 de octubre próximo, a partir de las 16:00 horas, en el Hotel Bellavista de Puerto Varas.
Especialistas participará en diferentes instancias de AQUASUR 2024, una de las dos ferias internacionales de Acuicultura más grandes del mundo.
AQUASUR 2024, la feria de acuicultura más importante del hemisferio sur, está generando grandes expectativas a medida que se acerca su inicio en los Terminales Marítimos de la Patagonia del 19 al 21 de marzo.
Congresos científicos, concursos para pymes y reconocimiento al bienestar animal, son parte de la oferta de valor que entregará la feria más importante del hemisferio sur.